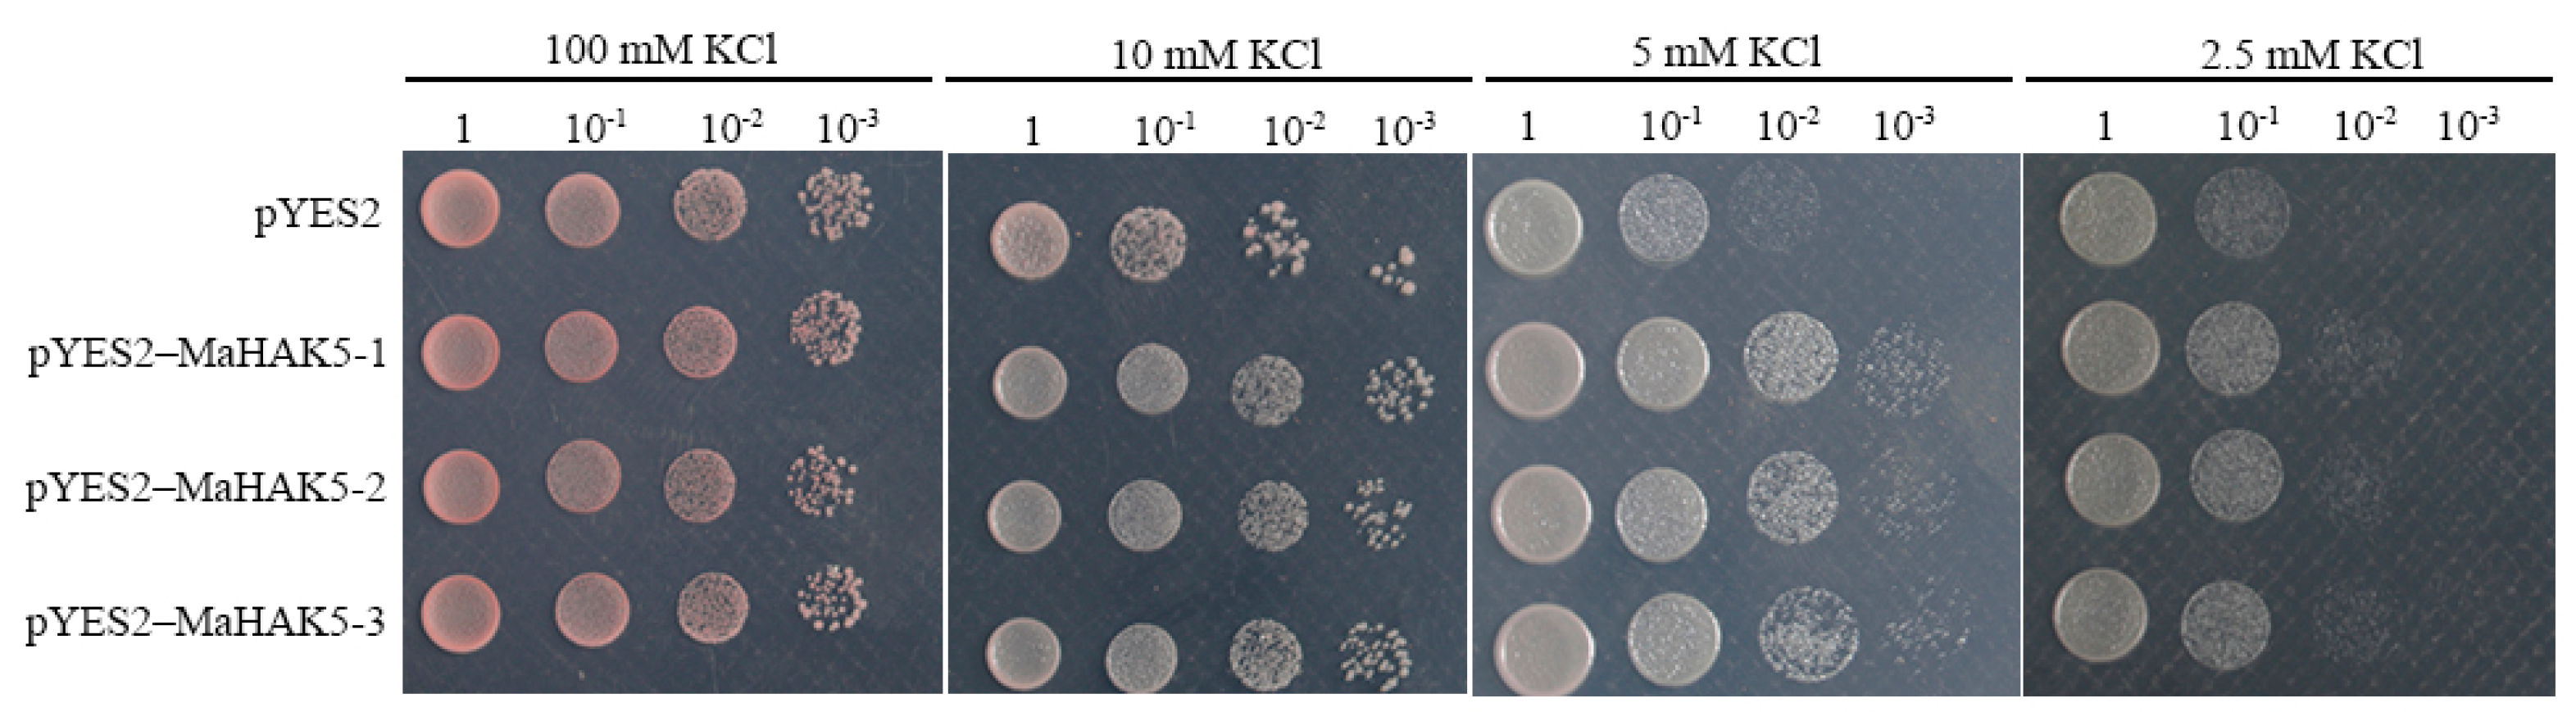

MaHAK5, a Potassium Transporter of Banana, Enhanced Potassium Uptake in Transgenic Arabidopsis under Low Potassium Conditions
Abstract
1. Introduction
2. Materials and Methods
3. Results
3.1. Cloning and Bioinformatic Analysis of MaHAK5
3.2. Subcellular Localization of the MaHAK5 Protein
3.3. MaHAK5 Functions in Potassium Uptake in Yeast
3.4. Expression Profile of MaHAK5 under Different K+ Concentrations
3.5. Overexpression of MaHAK5 Enhances K+ Uptake and Plant Growth in Arabidopsis
4. Discussion
5. Conclusions
Supplementary Materials
Author Contributions
Funding
Institutional Review Board Statement
Informed Consent Statement
Data Availability Statement
Conflicts of Interest
References
- Leigh, R.A.; Wyn Jones, R.G. A hypothesis relating critical potassium concentrations for growth to the distribution and functions of this ion in the plant cell. New Phytol. 1984, 97, 1–13. [Google Scholar] [CrossRef]
- Schachtman, D.P.; Schroeder, J.I. Structure and transport mechanism of a high-affinity potassium uptake transporter from higher plants. Nature 1994, 370, 655–658. [Google Scholar] [CrossRef] [PubMed]
- Glass, A.D.M. Regulation of ion transport. Annu. Rev. Plant. Physiol. 1983, 34, 311–326. [Google Scholar] [CrossRef]
- Maathuis, F.J.M.; Sanders, D. Plasma membrane transport in context—making sense out of complexity. Curr. Opin. Plant Biol. 1999, 2, 236–243. [Google Scholar] [CrossRef]
- Pettigrew, W.T. Potassium influences on yield and quality production for maize, wheat, soybean and cotton. Physiol. Plant. 2008, 133, 670–681. [Google Scholar] [CrossRef]
- Mengel, K. Effect of potassium on the assimilate conduction to storage tissue. Ber. Deutsch. Bot. Ges. Bd. 1980, 93, 353–362. [Google Scholar] [CrossRef]
- Britto, D.T.; Kronzucker, H.J. Cellular mechanisms of potassium transport in plants. Physiol. Plant. 2008, 133, 637–650. [Google Scholar] [CrossRef]
- Rüdiger Hell, R.-R.M. Cell Biology of metals and nutrients. Plant Cell Monogr. 2010, 17, 199–224. [Google Scholar] [CrossRef]
- Maathuis, F.J. Physiological functions of mineral macronutrients. Curr. Opin. Plant. Biol. 2009, 12, 250–258. [Google Scholar] [CrossRef]
- Epstein, E.; Rains, D.W.; Elzam, O.E. Resolution of dual mechanisms of potassium absorption by barley roots. Proc. Natl. Acad. Sci. USA 1963, 49, 684–692. [Google Scholar] [CrossRef]
- Very, A.A.; Nieves-Cordones, M.; Daly, M.; Khan, I.; Fizames, C.; Sentenac, H. Molecular biology of K+ transport across the plant cell membrane: What do we learn from comparison between plant species? J. Plant. Physiol. 2014, 171, 748–769. [Google Scholar] [CrossRef] [PubMed]
- Nieves-Cordones, M.; Martinez, V.; Benito, B.; Rubio, F. Comparison between Arabidopsis and rice for main pathways of K+ and Na+ uptake by roots. Front. Plant. Sci. 2016, 7, 992. [Google Scholar] [CrossRef] [PubMed]
- Maser, P.; Thomine, S.; Schroeder, J.I.; Ward, J.M.; Hirschi, K.; Sze, H.; Talke, I.N.; Amtmann, A.; Maathuis, F.J.; Sanders, D.; et al. Phylogenetic relationships within cation transporter families of Arabidopsis. Plant. Physiol. 2001, 126, 1646–1667. [Google Scholar] [CrossRef] [PubMed]
- Zhang, Z.; Zhang, J.; Chen, Y.; Li, R.; Wang, H.; Wei, J. Genome-wide analysis and identification of HAK potassium transporter gene family in maize (Zea mays L.). Mol. Biol. Rep. 2012, 39, 8465–8473. [Google Scholar] [CrossRef]
- Cheng, X.; Liu, X.; Mao, W.; Zhang, X.; Chen, S.; Zhan, K.; Bi, H.; Xu, H. Genome-wide identification and analysis of HAK/KUP/KT potassium transporters gene family in wheat (Triticum aestivum L.). Int. J. Mol. Sci. 2018, 19, 3969. [Google Scholar] [CrossRef]
- Pyo, Y.J.; Gierth, M.; Schroeder, J.I.; Cho, M.H. High-affinity K+ transport in Arabidopsis: AtHAK5 and AKT1 are vital for seedling establishment and postgermination growth under low-potassium conditions. Plant. Physiol. 2010, 153, 863–875. [Google Scholar] [CrossRef]
- Yang, T.; Zhang, S.; Hu, Y.; Wu, F.; Hu, Q.; Chen, G.; Cai, J.; Wu, T.; Moran, N.; Yu, L.; et al. The role of a potassium transporter OsHAK5 in potassium acquisition and transport from roots to shoots in rice at low potassium supply levels. Plant. Physiol. 2014, 166, 945–959. [Google Scholar] [CrossRef]
- Qin, Y.J.; Wu, W.H.; Wang, Y. ZmHAK5 and ZmHAK1 function in K+ uptake and distribution in maize under low K+ conditions. J. Integr. Plant Biol. 2019, 61, 691–705. [Google Scholar] [CrossRef]
- Smithson, P.C.; McIntyre, B.D.; Gold, C.S.; Ssali, H.; Night, G.; Okech, S. Potassium and magnesium fertilizers on banana in Uganda: Yields, weevil damage, foliar nutrient status and DRIS analysis. Nutr. Cycl. Agroecosystems 2004, 69, 43–49. [Google Scholar] [CrossRef]
- Aurivan, S.d.F.; Edson, A.P.; Adélia, A.A.P.; Maria, G.d.O.S.; Humberson, R.S.; Cristian, D.P.P. Interaction between potassium (K) and calcium (Ca) on the severity of Yellow Sigatoka in banana plants. Afr. J. Agric. Res. 2017, 12, 1353–1361. [Google Scholar] [CrossRef][Green Version]
- Qin, Y.; Zhang, Z.; Liu, C. Effects of the combination of bio-fertilizer and potassium fertilizer on control of banana Fusariumwilt. Plant Prot. 2017, 43, 65–69. [Google Scholar] [CrossRef]
- Clough, S.J.; Bent, A.F. Floral dip: A simplified method for Agrobacterium-mediated transformation of Arabidopsis thaliana. Plant J. 1998, 16, 735–743. [Google Scholar] [CrossRef] [PubMed]
- Kumar, S.; Stecher, G.; Li, M.; Knyaz, C.; Tamura, K. MEGA X: Molecular Evolutionary Genetics Analysis across Computing Platforms. Mol. Biol. Evol. 2018, 35, 1547–1549. [Google Scholar] [CrossRef] [PubMed]
- Chen, L. Functional analysis of four potassium transporters genes in rice HAK family. Master’s Thesis, Nanjing Agricultural University, Nanjing, China, 2012. [Google Scholar]
- Feng, C.Z.; Luo, Y.X.; Wang, P.D.; Gilliham, M.; Long, Y. MYB77 regulates high-affinity potassium uptake by promoting expression of HAK5. New Phytol. 2021, 232, 176–189. [Google Scholar] [CrossRef]
- Mackinney, G. Absorption of light by chlorophyll solutions. J. Biol. Chem. 1941, 140, 315–322. [Google Scholar] [CrossRef]
- Wang, T.T.; Ren, Z.J.; Liu, Z.Q.; Feng, X.; Guo, R.Q.; Li, B.G.; Li, L.G.; Jing, H.C. SbHKT1; 4, a member of the high-affinity potassium transporter gene family from Sorghum bicolor, functions to maintain optimal Na+/K+ balance under Na+ stress. J. Integr. Plant Biol. 2014, 56, 315–332. [Google Scholar] [CrossRef]
- Liu, S.; Wu, B.; Xie, Y.; Zheng, S.; Xie, J.; Wang, W.; Xiang, D.; Li, C. Genome-wide analysis of HAK/KUP/KT potassium transporter genes in banana (Musa acuminata L.) and their tissue-specific expression profiles under potassium stress. Plant Growth Regul. 2022, 97, 51–60. [Google Scholar] [CrossRef]
- Yang, T.; Feng, H.; Zhang, S.; Xiao, H.; Hu, Q.; Chen, G.; Xuan, W.; Moran, N.; Murphy, A.; Yu, L.; et al. The potassium transporter OsHAK5 alters rice architecture via ATP-Dependent transmembrane auxin fluxes. Plant Commun. 2020, 1, 100052. [Google Scholar] [CrossRef]
- Gierth, M.; Maser, P.; Schroeder, J.I. The potassium transporter AtHAK5 functions in K+ deprivation-induced high-affinity K+ uptake and AKT1 K+ channel contribution to K+ uptake kinetics in Arabidopsis roots. Plant. Physiol. 2005, 137, 1105–1114. [Google Scholar] [CrossRef]

Disclaimer/Publisher’s Note: The statements, opinions and data contained in all publications are solely those of the individual author(s) and contributor(s) and not of MDPI and/or the editor(s). MDPI and/or the editor(s) disclaim responsibility for any injury to people or property resulting from any ideas, methods, instructions or products referred to in the content. |
© 2022 by the authors. Licensee MDPI, Basel, Switzerland. This article is an open access article distributed under the terms and conditions of the Creative Commons Attribution (CC BY) license (https://creativecommons.org/licenses/by/4.0/).
Share and Cite
Wu, B.; Xie, Y.; Xiang, D.; Yi, G.; Liu, H.; Li, C.; Liu, S. MaHAK5, a Potassium Transporter of Banana, Enhanced Potassium Uptake in Transgenic Arabidopsis under Low Potassium Conditions. Horticulturae 2023, 9, 10. https://doi.org/10.3390/horticulturae9010010
Wu B, Xie Y, Xiang D, Yi G, Liu H, Li C, Liu S. MaHAK5, a Potassium Transporter of Banana, Enhanced Potassium Uptake in Transgenic Arabidopsis under Low Potassium Conditions. Horticulturae. 2023; 9(1):10. https://doi.org/10.3390/horticulturae9010010
Chicago/Turabian StyleWu, Bangting, Yanling Xie, Dandan Xiang, Ganjun Yi, Hong Liu, Chunyu Li, and Siwen Liu. 2023. "MaHAK5, a Potassium Transporter of Banana, Enhanced Potassium Uptake in Transgenic Arabidopsis under Low Potassium Conditions" Horticulturae 9, no. 1: 10. https://doi.org/10.3390/horticulturae9010010
APA StyleWu, B., Xie, Y., Xiang, D., Yi, G., Liu, H., Li, C., & Liu, S. (2023). MaHAK5, a Potassium Transporter of Banana, Enhanced Potassium Uptake in Transgenic Arabidopsis under Low Potassium Conditions. Horticulturae, 9(1), 10. https://doi.org/10.3390/horticulturae9010010

